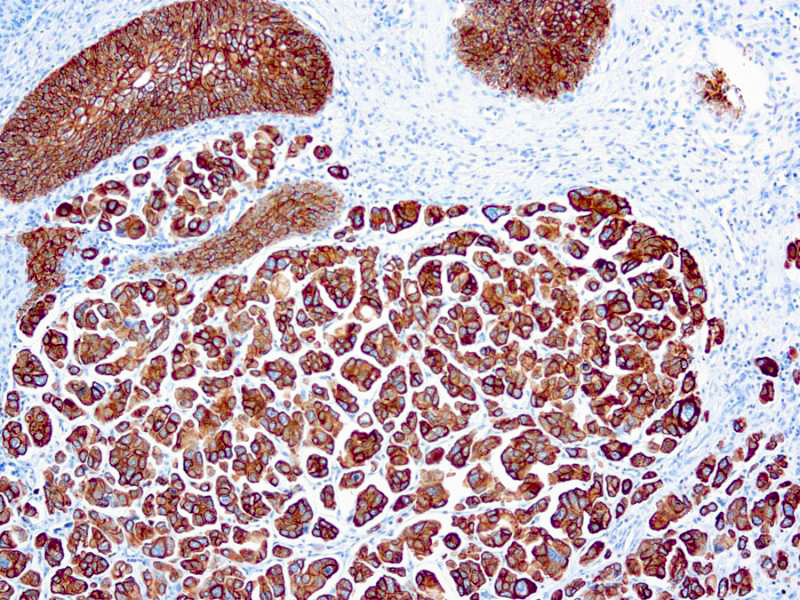

Keratins are cytoplasmic intermediate filament proteins expressed by epithelial cells. Cytokeratin 7 (CK7) is expressed in a wide range of epithelial structures in humans. CK7 occurs in the columnar and glandular epithelium of the lug, cervix, breast, in bile ducts, collecting ducts in the kidney and mesothelium, but is absent in gastrointestinal epithelium, hepatocytes, proximal and distal tubules of the kidney and myoepithelium. The antibody OVTL 12/30 is an excellent tool in the differential diagnosis of malignant cells and to determine primary tumor localization. It stains a 54kD protein band of cytoskeletal proteins from cell lines in one and two dimensional immunoblots.
Cytokeratin 7
SKU: 8379
Categories: Primary Antibodies, IVD - For U.S. Market, IVD - Outside U.S. Market
Tags: Highlighter Product, HL72K-Core Kit, Concentrated, C
Description
Additional information
| Clone | OV-TL 12/30 |
|---|---|
| Isotype | IgG1, kappa |
| Immunogen | BALB/C mice were immunized with ovarian carcinoma cell line, OTN11. |
| Species | Mouse |
| Cellular Localization | Cytoplasmic |
| Positive Control Tissue | Breast, Lung |
| Pretreatment | Citrate Buffer pH 6.0 (Manual/ Montage) |
| Incubation & Temperature | 30 min @ RT |
| Intended Use | IVD |
| Detection System | PolyVue™ Plus – Two Step Detection System or Montage PolyVue Plus™ Auto Detection System for Montage 360 System or HighLighter core kit for HighLighter Staining System |
| Description/Type | Mouse Monoclonal Antibody |
| Format | This product is supplied as a purified immunoglobulin and contains sodium azide as a preservative. |
DATASHEETS & SDS
DATASHEETS & SDS
| Download Datasheet |
| Download SDS Sheet – OSHA |
REFERENCES
REFERENCES
- Van Niekerk, C.C, et al., 1991,1. Pathol. 165, 145.
- Ftarnaekers. F.CS., et al., 1990 Arn 1. Pathol. 136, 641.
- Van Niekerk, C.C, et al., 1989, Int. J. Cancer 43, 1065.
- Van Niekerk, C.C. et al., 1991, Am 1. Pathol. 138, 455.
- Smedts. F., et al., 1994, Virchows Archives 425, 145-155.
Reviews (0)
Only logged in customers who have purchased this product may leave a review.

Reviews
There are no reviews yet.